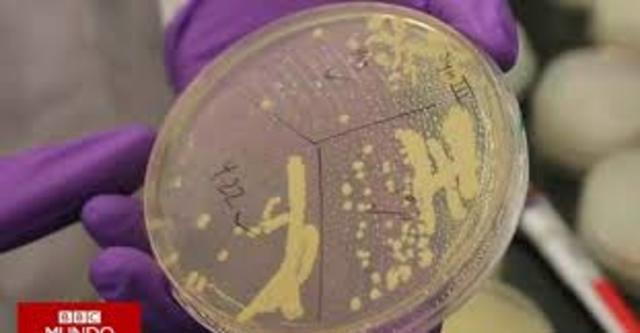
Cromosoma sintetico  2008

-
Investigó el papel del núcleo y el citoplasma en el desarrollo embrionario. Su gran objetivo consistió en desentrañar las relaciones fisiológicas entre la estructura y los procesos celulares. Sus trabajos con erizos de mar mostraron que era necesario que todos los cromosomas estuvieran presentes para que un desarrollo embrionario correcto tuviera lugar. Este descubrimiento fue parte importante de la teoría cromosómica de Sutton y Boveri.
-
Fue un genetista estadounidense trabajó intensamente en un programa de reproducción y cruce de miles de moscas de la fruta en un cuarto que pasó a llamarse el Cuarto de la Mosca Intentó hacer mutar las moscas con diversos medios rayos x etc. Aplicó los principios mendelianos en las moscas. El estudio de herencia realizado por Morgan demostró la herencia ligada al sexo, y es una de las primeras evidencias que confirman la teoría cromosómica de la herencia basada en el cruzamiento.
-
Fue un bioquímico ruso-estadounidense que estudió la estructura y función de los ácidos nucleicos. Él caracterizó las diferentes formas de ácidos nucleicos, ADN de ARN, y encontró que el ADN contenía adenina, guanina, timina, citosina, desoxirribosa, y un grupo fosfato.
-
el microbiólogo desarrollo experimentos que demostraron que las bacterias eran capaces de transferir información genética mediante un proceso llamado transformación. Investigar una enfermedad infecciosa mortal, la neumonía, estudiar las diferencias entre una bacteria Streptococcus pneumoniae que produce la enfermedad y otra que no la causaba.
-
Fue un biólogo Danés-Alemán determinó que el núcleo de una célula controla el desarrollo de los organismos conteniendo la información hereditaria, o ADN. Su experimentación con las algas verdes Acetabularia proveyó un modelo de objeto para la investigación biológica moderna de la célula, y probó la existencia de sustancias morfogenéticas, o mRNP.
-
fue un citólogo y genetista sueco hizo varias contribuciones claves a la biología. en 1934, él y Einar Hammarsten demostraron que el ADN era un polímero. Las teorías anteriores sugerían que cada molécula tenía solo diez nucleótidos de longitud.estudió por primera vez el material genético dentro de una célula con un microscopio ultravioleta el contenido de ácido nucleico de las estructuras celulares como el núcleo y el nucleolo utilizando la reacción de Feulgen a mancha el ADN.
-
Fue un físico inglés y biólogo molecular que realizó estudios pioneros sobre la difracción de rayos X en moléculas biológicas. Su trabajo sobre la queratina proporcionó la base para el descubrimiento de la hélice alfa de Linus Pauling. También estudió la estructura del ADN en 1937 y dio el primer paso en la elucidación de su estructura.
-
Los experimentos implicaban exponer el moho Neurospora crassa a rayos X, causando mutaciones. En varias series de experimentos, demostraron que esas mutaciones causaron cambios en las enzimas específicas implicadas en las rutas metabólicas. Estos experimentos, publicados en 1941 los llevaron a proponer un vínculo directo entre los genes y las reacciones enzimáticas conocida como la hipótesis «Un gen, una enzima»
-
analizó las bases nitrogenadas del ADN en diferentes formas de vida, concluyendo que, la cantidad de purinas no siempre se encontraban en proporciones iguales a las de las pirimidinas (contrariamente a lo propuesto por Levene), la proporción era igual en todas las células de los individuos de una especie dada, pero variaba de una especie a otra.
-
Junto a Martha Chase, confirman que es el ADN la base del material genético, y no las proteínas. Este trabajo será recordado como el experimento de Hershey y Chase.
Por sus trabajos sobre el mecanismo de replicación de los virus y su estructura genética se le otorga el Premio Nobel de Fisiología o Medicina en 1969 que compartió con Salvador Edward Luria y Max Ludwig Henning Delbrück. -
Fue un físico, biólogo molecular y neurocientífco , por sus descubrimientos concernientes a la estructura molecular de los ácidos desoxirribonucleicos (ADN) y su importancia para la transferencia de información en la materia viva"
-
Fue un citogenetista de origen indonesio. Descubrió que el número normal de cromosomas humanos es 46 (y no 48 como se pensaba hasta entonces). Este hito de la genética tuvo lugar el 22 de diciembre de 1955 en el Instituto de Genética de la Universidad de Lund en Suecia, donde Tjio era un científico visitante.
-
Originalmente especializado en citología de plantas , Levan luego recurrió a las similitudes en la estructura cromosómica de las células cancerosas y los errores introducidos en las células vegetales a través de elementos químicos o radiactivos. Estos estudios llevaron luego al examen de cromosomas en células animales.Levan fue elegido miembro de la Real Academia Sueca de Ciencias en 1967.
-
Famoso por ser uno de los dos descubridores de la estructura molecular del ADN en 1953, junto con el biofísico británico Francis Crick, lo que le valió el reconocimiento de la comunidad científica a través del Premio Nobel en Fisiología o Medicina.
-
Fue un experimento realizado en 1957 por Matthew Meselson y Franklin Stahl en el que se demostró que la replicación de ADN era semiconservadora. Una replicación semiconservadora es aquella en que la cadena de dos filamentos en hélice del ADN se replica de forma tal que cada una de las dos cadenas de ADN formadas consisten en un filamento proveniente de la hélice original y un filamento nuevo sintetizado.
-
Estudio el resultado fue la comprensión sobre como los alimentos son convertidos en material celular, a través del uso de carbonos isotópicos o átomos nitrogenados pesados. Su tesis doctoral es ahora conocida como la conversión de ácido fórmico, formaldehído y metanol para reducir completamente los grupos de metilo a metionina. Fue también uno de los primeros en demostrar que los cofactores del ácido fólico y la vitamina B12 tenían influencia en los procesos mencionados.
-
La insulina humana es una proteína de actividad hormonal que regula los niveles de glucosa en sangre. Cuando la insulina falla se desarrolla el padecimiento conocido como diabetes. La insulina se ha expresado en bacterias, levaduras, hongos, células animales y sistemas vegetales por biotecnología vegetal. En este trabajo presentamos los resultados del uso de raíces transformadas de Brassica oleracea var italica (Brocoli) para producir insulina humana.
-
Fue una célula donante diferenciada a un óvulo no fecundado y anucleada. La célula de la que venía Dolly era una ya diferenciada o especializada, procedente de un tejido concreto, la glándula mamaria, de un animal adulto lo cual suponía una novedad. se creía que solo se podían obtener clones de una célula embrionaria, es decir, no especializada. 5 meses después nacía Dolly, que fue el único cordero resultante de 277 fusiones de óvulos anucleados con núcleos de células mamarias.
-
Se logra hacer el primer trasplante de un genoma completo de una bacteria hacia otra bacteria.
-
Crean el primer cromosoma artificial de la historia a partir de levadura de un pan. creado por un grupo de científicos
Looking for a timeline maker?
Create timelines for projects, roadmaps, history, lessons, legal cases, and stories with Timetoast. Timetoast is a timeline maker for work, school, research, and stories.